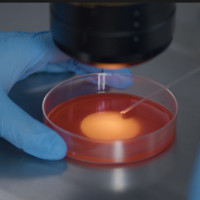
Почему беременность не наступает: репродуктологи Ecofamily Clinic разберут на открытой встрече 14 февраля

Компании «Лебер» и ГК «Рики» объявляют о начале сотрудничества: миры «Малышариков» и других проектов оживут на детских площадках
Ведущий российский производитель детских и спортивных площадок, компания «Лебер», и группа компаний «Рики», создатель таких популярных анимационных франшиз, как «Смешарики», «Малышарики», «Фиксики», «Финник» и других, подписали договор о сотрудничестве. Целью партнерства является создание инновационных игровых простран